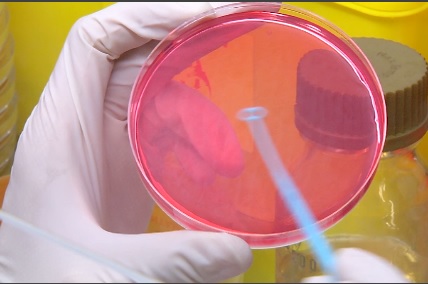
АНТИБИОТИК-ДЛЯ-РЫБ

Франсиско Масиас – профессор органической химии и один из первых ученых в Испании, начавших заниматься аллелопатией или биохимическим взаимодействием между растениями. «Главная задача ученого – порождать знания. А знания, естественно, находят практическое применение.» Возможностей применить знания в этой области много. Антонио Масиас руководит Научной группа аллелопатии в Университете Кадиса. Предметом изучения ученых являются, в частности, […]